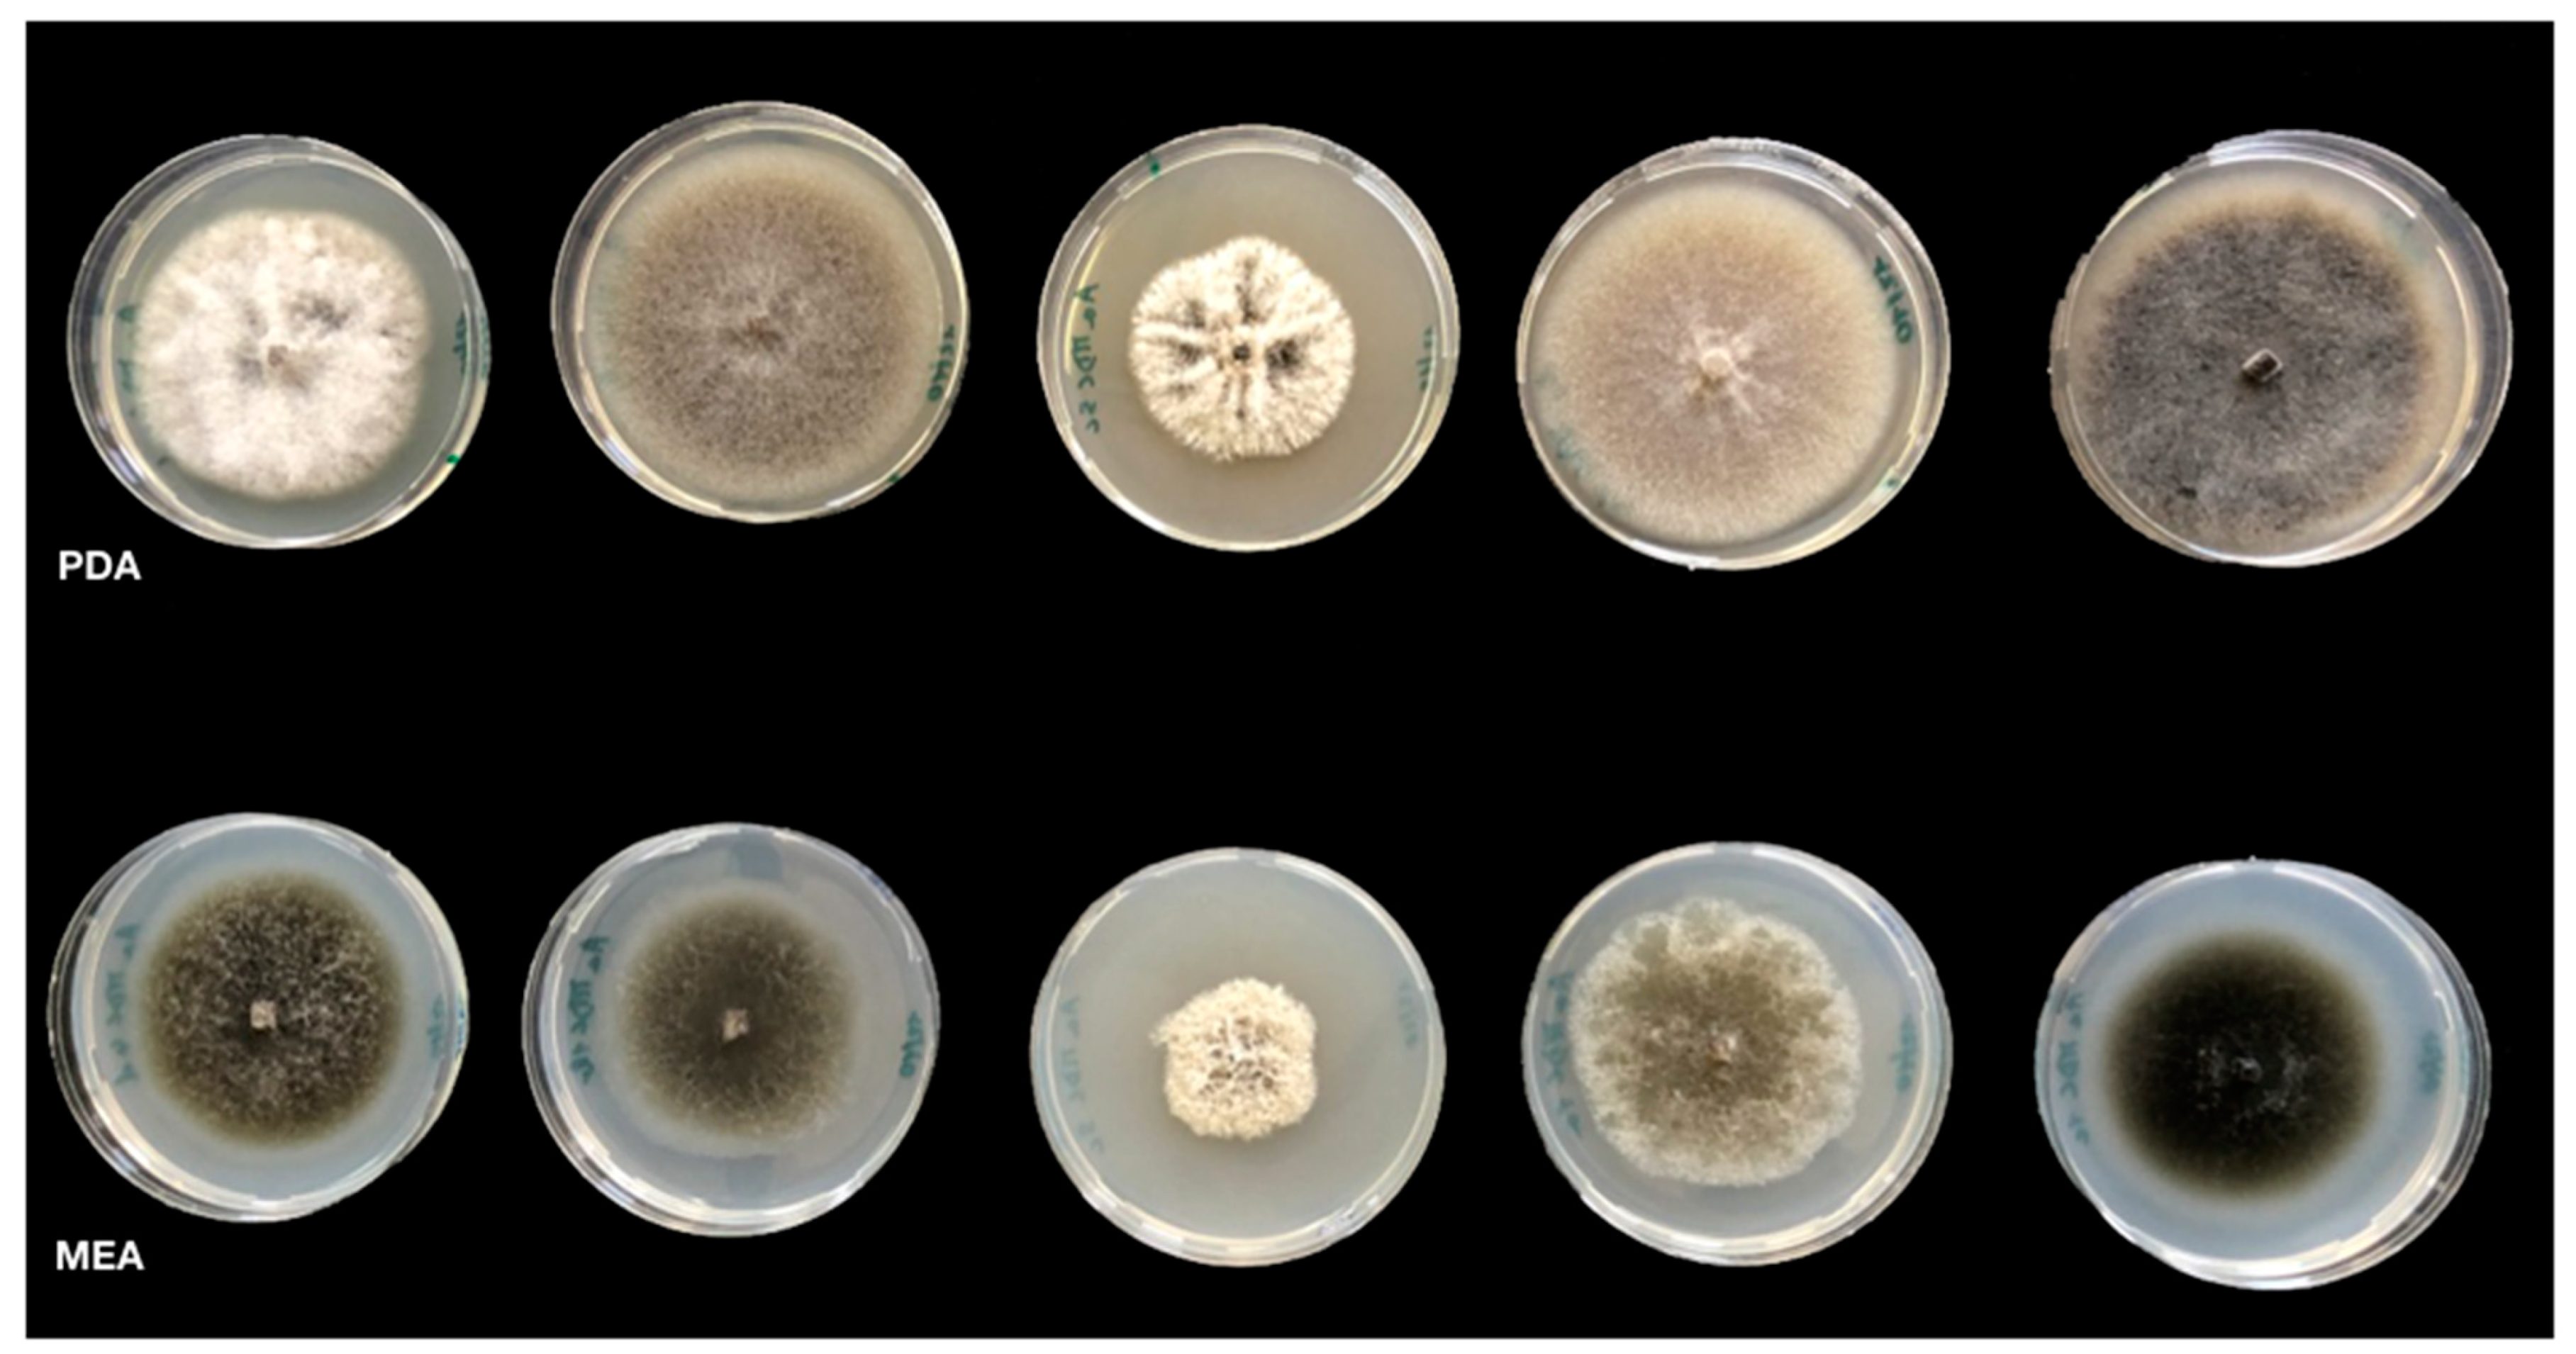

Characterization of Alternaria Species Associated with Heart Rot of Pomegranate Fruit
Abstract
1. Introduction
2. Materials and Methods
2.1. Alternaria Isolates
2.2. Symptoms, Distribution and Incidence of the Disease
2.3. Morphological Characterization
2.4. Molecular Characterization
2.5. Pathogenicity Tests
2.6. Extraction and Analyses of Secondary Metabolites
3. Results
3.1. Morphological Characterization of Isolates
3.2. Molecular Characterization
3.3. Pathogenicity Tests
3.4. Analyses of Alternaria Mycotoxins
4. Discussion
5. Conclusions
Author Contributions
Funding
Institutional Review Board Statement
Informed Consent Statement
Data Availability Statement
Acknowledgments
Conflicts of Interest
References
- Faedda, R.; Granata, G.; Cocuzza, G.E.M.; Giudice, V.L.; Audoly, G.; Pane, A.; Cacciola, S.O. First report of heart rot of pomegranate (Punica granatum) caused by Alternaria alternata in Italy. Plant Dis. 2015, 99, 1446. [Google Scholar] [CrossRef]
- Istat.it. Available online: http://dati.istat.it/Index.aspx?QueryId=33705 (accessed on 18 September 2020).
- Wang, R.; Ding, Y.; Liu, R.; Xiang, L.; Du, L. Pomegranate: Constituents, bioactivities and fharmacokinetics. In Pomegranate, Fruit, Vegetable and Cereal Science and Biotechnology; Chandra, R., Ed.; National Research Center on Pomegranate: Solapur, India, 2010; pp. 77–87. [Google Scholar]
- Tehranifar, A.; Selahvarzi, Y.; Kharrazi, M.; Bakhsh, V.J. High potential of agro-industrial by-products of pomegranate (Punica granatum L.) as the powerful antifungal and antioxidant substances. Ind. Crop. Prod. 2011, 34, 1523–1527. [Google Scholar] [CrossRef]
- Pangallo, S.; Li Destri Nicosia, M.G.; Agosteo, G.E.; Abdelfattah, A.; Romeo, F.V.; Cacciola, S.O.; Rapisarda, P.; Schena, L. Evaluation of a pomegranate peel extract as an alternative means to control olive anthracnose. Phytopathology 2017, 107, 1462–1467. [Google Scholar] [CrossRef]
- Pangallo, S.; Nicosia, M.G.L.D.; Raphael, G.; Levin, E.; Ballistreri, G.; Cacciola, S.O.; Rapisarda, P.; Droby, S.; Schena, L. Elicitation of resistance responses in grapefruit and lemon fruits treated with a pomegranate peel extract. Plant Pathol. 2017, 66, 633–640. [Google Scholar] [CrossRef]
- Belgacem, I.; Pangallo, S.; Abdelfattah, A.; Romeo, F.V.; Cacciola, S.O.; Li Destri Nicosia, M.G.; Ballistreri, G.; Schena, L. Transcriptomic analysis of orange fruit treated with pomegranate peel extract (PGE). Plants 2019, 8, 101. [Google Scholar] [CrossRef]
- Chen, J.; Liao, C.; Ouyang, X.; Kahramanoǧlu, I.; Gan, Y.; Li, M. Antimicrobial activity of pomegranate peel and its applications on food preservation. J. Food Qual. 2020, 8850339. [Google Scholar] [CrossRef]
- Magangana, T.P.; Makunga, N.P.; Fawole, O.A.; Opara, U.L. Processing factors affecting the phytochemical and nutritional properties of pomegranate (Punica granatum L.) peel waste: A review. Molecules 2020, 25, 4690. [Google Scholar] [CrossRef]
- Pangallo, S.; Nicosia, M.G.L.D.; Scibetta, S.; Strano, M.C.; Cacciola, S.O.; Agosteo, G.E.; Belgacem, I.; Schena, L. Pre- and postharvest applications of a pomegranate peel extract to control citrus fruit decay during storage and shelf life. Plant Dis. 2020. [Google Scholar] [CrossRef] [PubMed]
- Tziros, G.T.; Lagopodi, A.L.; Tzavella-Klonari, K. Alternaria alternata fruit rot of pomegranate (Punica granatum) in Greece. Plant Pathol. 2008, 57, 379. [Google Scholar] [CrossRef]
- Thomidis, T. Fruit rots of pomegranate (cv. Wonderful) in Greece. Australas. Plant Pathol. 2014, 43, 583–588. [Google Scholar] [CrossRef]
- Ezra, D.; Kirshner, B.; Hershcovich, M.; Shtienberg, D.; Kosto, I. Heart rot of pomegranate: Disease etiology and the events leading to development of symptoms. Plant Dis. 2015, 99, 496–501. [Google Scholar] [CrossRef] [PubMed]
- Luo, Y.; Hou, L.; Förster, H.; Pryor, B.; Adaskaveg, J.E. Identification of Alternaria species causing heart rot of pomegranates in California. Plant Dis. 2017, 101, 421–427. [Google Scholar] [CrossRef]
- Benagi, V.I.; Ravi Kumar, M.R.; Gowdar, S.B.; Pawar, B.B. Survey on diseases of pomegranate in Northern Karnataka, India. Acta Hortic. 2011, 890, 509–511. [Google Scholar] [CrossRef]
- Day, K.R.; Wilkins, E.D. Commercial pomegranate (Punica granatum L.) production in California. Acta Hortic. 2011, 890, 275–285. [Google Scholar] [CrossRef]
- Zhang, L.; McCarthy, M.J. Black heart characterization and detection in pomegranate using NMR relaxometry and MR imaging. Postharvest Biol. Technol. 2012, 67, 96–101. [Google Scholar] [CrossRef]
- Michailides, T.; Morgan, D.; Quist, M.; Reyes, H. Infection of pomegranate by Alternaria spp. causing black heart. Phytopathology 2008, 98, S105. [Google Scholar]
- Garganese, F.; Schena, L.; Siciliano, I.; Prigigallo, M.I.; Spadaro, D.; dD Grassi, A.; Ippolito, A.; Sanzani, S.M. Characterization of citrus-associated Alternaria species in Mediterranean areas. PLoS ONE 2016, 11, e0163255. [Google Scholar] [CrossRef]
- Woudenberg, J.H.C.; Seidl, M.F.; Groenewald, J.Z.; de Vries, M.; Stielow, J.B.; Thomma, B.P.H.J.; Crous, P.W. Alternaria section Alternaria: Species, formae speciales or pathotypes? Stud. Mycol. 2015, 82. [Google Scholar] [CrossRef]
- Lawrence, D.P.; Rotondo, F.; Gannibal, P.B. Biodiversity and taxonomy of the pleomorphic genus Alternaria. Mycol. Prog. 2016, 15. [Google Scholar] [CrossRef]
- Patriarca, A. Alternaria in food products. Curr. Opin. Food Sci. 2016, 11. [Google Scholar] [CrossRef]
- Simmons, E.G. Alternaria themes and variations (236–243) host-specific toxin producers. Mycotaxon 1999, 70, 325–369. [Google Scholar]
- Simmons, E.G. Alternaria. In An Identification Manual: Fully Illustrated and with Catalogue Raisonné 1796–2007; Simmons, E.G., Ed.; CBS Fungal Biodiversity Centre: Utrecht, The Netherlands, 2007. [Google Scholar]
- Andrew, M.; Peever, T.L.; Pryor, B.M. An expanded multilocus phylogeny does not resolve morphological species within the small-spored Alternaria species complex. Mycologia 2009, 101, 95–109. [Google Scholar] [CrossRef]
- Armitage, A.D.; Barbara, D.J.; Harrison, R.J.; Lane, C.R.; Sreenivasaprasad, S.; Woodhall, J.W.; Clarkson, J.P. Discrete lineages within Alternaria alternata species group: Identification using new highly variable loci and support from morphological characters. Fungal Biol. 2015, 119, 994–1006. [Google Scholar] [CrossRef] [PubMed]
- Kusaba, M.; Tsuge, T. Philogeny of Alternaria fungi known to produce host-specific toxins on the basis of variation in internal transcribed spacers of ribosomal DNA. Curr. Genet. 1995, 28, 491–498. [Google Scholar] [CrossRef]
- Johnson, L.J.; Johnson, R.D.; Akamatsu, H.; Salamiah, A.; Otani, H.; Kohmoto, K.; Kodama, M. Spontaneous loss of a conditionally dispensable chromosome from the Alternaria alternata apple pathotype leads to loss of toxin production and pathogenicity. Curr. Genet. 2001, 40, 65–72. [Google Scholar] [CrossRef] [PubMed]
- Peever, T.L.; Su, G.; Carpenter-Boggs, L.; Timmer, L.W. Molecular systematics of citrus-associated Alternaria species. Mycologia 2004, 96, 119–134. [Google Scholar] [CrossRef] [PubMed]
- Pryor, B.M.; Bigelow, D.M. Molecular characterization of Embellisia and Nimbya species and their relationship to Alternaria, Ulocladium and Stemphylium. Mycologia 2003, 95, 1141–1154. [Google Scholar] [CrossRef]
- Pryor, B.M.; Gilbertson, R.L. Molecular phylogenetic relationships amongst Alternaria species and related fungi based upon analysis of nuclear ITS and mt SSU rDNA sequences. Mycol. Res. 2000, 104, 1312–1321. [Google Scholar] [CrossRef]
- Andersen, B.; Nielsen, K.F.; Pinto, V.F.; Patriarca, A. Characterization of Alternaria strains from Argentinean blueberry, tomato, walnut and wheat. Int. J. Food Microbiol. 2015, 196. [Google Scholar] [CrossRef]
- Logrieco, A.; Moretti, A.; Solfrizzo, M. Alternaria toxins and plant diseases: An overview of origin, occurrence and risks. World Mycotoxin J. 2009, 2, 129–140. [Google Scholar] [CrossRef]
- Prelle, A.; Spadaro, D.; Garibaldi, A.; Gullino, M.L. A new method for detection of five Alternaria toxins in food matrices based on LC-APCI-MS. Food Chem. 2013, 140, 161–167. [Google Scholar] [CrossRef] [PubMed]
- Siciliano, I.; Ortu, G.; Gilardi, G.; Gullino, M.L.; Garibaldi, A. Mycotoxin production in liquid culture and on plants infected with Alternaria spp. isolated from rocket and cabbage. Toxins 2015, 7, 743–754. [Google Scholar] [CrossRef] [PubMed]
- Escrivá, L.; Oueslati, S.; Font, G.; Manyes, L. Alternaria Mycotoxins in food and feed: An Overview. J. Food Qual. 2017, 5. [Google Scholar] [CrossRef]
- Fraeyman, S.; Croubels, S.; Devreese, M.; Antonissen, G. Emerging Fusarium and Alternaria mycotoxins: Occurrence, toxicity and toxicokinetics. Toxins 2017, 9, 228. [Google Scholar] [CrossRef]
- Masiello, M.; Somma, S.; Susca, A.; Ghionna, V.; Logrieco, A.F.; Franzoni, M.; Ravaglia, S.; Meca, G.; Moretti, A. Molecular identification and mycotoxin production by Alternaria species occurring on durum wheat, showing black point symptoms. Toxins 2020, 12, 275. [Google Scholar] [CrossRef] [PubMed]
- Hickert, S.; Bergmann, M.; Ersen, S.; Cramer, B.; Humpf, H.U. Survey of Alternaria toxin contamination in food from the German market, using a rapid HPLC-MS/MS approach. Mycotoxin Res. 2016, 32, 7–18. [Google Scholar] [CrossRef]
- Thomma, B.P.H.J. Alternaria spp.: From general saprophyte to specific parasite. Mol. Plant Pathol. 2003, 4, 225–236. [Google Scholar] [CrossRef]
- EFSA Panel on Contaminants in the Food Chain. Scientific opinion on the risks for animal and public health related to the presence of Alternaria toxins in feed and food. EFSA J. 2011, 9, 2407. [Google Scholar] [CrossRef]
- Holland, D.; Hatib, K.; Bar-Ya’akov, I. Pomegranate: Botany, horticulture, breeding. Hortic. Rev. 2009, 35, 127–191. [Google Scholar]
- Pareek, S.; Valero, D.; Serrano, M. Postharvest biology and technology of pomegranate. J. Sci. Food Agric. 2015, 95, 2360–2379. [Google Scholar] [CrossRef]
- Prasad, R.N.; Chandra, R.; da Silva, J.A.T. Postharvest handling and processing of pomegranate. In Pomegranate, Fruit, Vegetable and Cereal Science and Biotechnology; Chandra, R., Ed.; Global Science Books: Solapur, India, 2010; pp. 88–95. [Google Scholar]
- Crous, P.W.; Verkley, G.J.M.; Groenwald, E.; Houbraken, J. Fungal Biodiversity, Westerdijk Laboratory Manual Series Vol.1; Westerdijk Fungal Biodiversity Institute: Utrecht, The Netherlands, 2009. [Google Scholar]
- Pryor, B.M.; Michailides, T.J. Morphological, pathogenic, and molecular characterization of Alternaria isolates associated with alternaria late blight of pistachio. Phytopathology 2002, 92, 406–416. [Google Scholar] [CrossRef]
- White, T.J.; Bruns, T.; Lee, S.; Taylor, J.W. Amplification and direct sequencing of fungal ribosomal RNA genes for phylogenetics. In PCR Protocols: A guide to Methods and Applications; Innis, M.A., Gelfand, D.H., Sninsky, J.J., White, T.J., Eds.; Academic Press, Inc.: San Diego, CA, USA, 1990; Volume 18, pp. 315–322. [Google Scholar]
- Carbone, I.; Kohn, L.M. A method for designing primer sets for speciation studies in filamentous ascomycetes. Mycologia 1999, 91, 553–556. [Google Scholar] [CrossRef]
- Berbee, M.L.; Pirseyedi, M.; Hubbard, S. Cochliobolus phylogenetics and the origin of known, highly virulent pathogens, inferred from ITS and glyceraldehyde-3-phosphate dehydrogenase gene sequences. Mycologia 1999, 91, 964–977. [Google Scholar] [CrossRef]
- FinchTV v.1.4.0. Available online: https://digitalworldbiology.com/FinchTV (accessed on 18 May 2020).
- Elim Dupes Software. Available online: http://hcv.lanl.gov/content/sequence/ELIMDUPES/elimdupes.html (accessed on 15 June 2020).
- Hall, M.P.; Nagel, R.J.; Fagg, W.S.; Shiue, L.; Cline, M.S.; Perriman, R.J.; Donohue, J.P.; Ares, M. Quaking and PTB control overlapping splicing regulatory networks during muscle cell differentiation. RNA 2013, 19, 627–638. [Google Scholar] [CrossRef]
- Troncoso-Rojas, R.; Tiznado-Hernández, M.E. Alternaria alternata (Black Rot, Black Spot). In Postharvest Decay: Control Strategies; Academic Press: Cambridge, MA, USA, 2014; pp. 147–187. ISBN 9780124115682. [Google Scholar]
- Faedda, R.; D’Aquino, S.; Granata, G.; Pane, A.; Palma, A.; Sanzani, S.M.; Schena, L.; Cacciola, S.O. Postharvest fungal diseases of cactus pear fruit in southern Italy. Acta Hortic. 2016, 1144, 215–218. [Google Scholar] [CrossRef]
- Wang, F.; Saito, S.; Michailides, T.; Xiao, C.-L. Phylogenetic, morphological, and pathogenic characterization of Alternaria species associated with fruit rot of mandarin in California. Plant Dis. 2020. [Google Scholar] [CrossRef] [PubMed]
- Masunaka, A.; Ohtani, K.; Peever, T.L.; Timmer, L.W.; Tsuge, T.; Yamamoto, M.; Yamamoto, H.; Akimitsu, K. An isolate of Alternaria alternata that is pathogenic to both tangerines and rough lemon and produces two host-selective toxins, ACT- and ACR-toxins. Phytopathology 2005, 95, 241–247. [Google Scholar] [CrossRef]
- Pinto, V.E.F.; Patriarca, A. Alternaria species and their associated mycotoxins. In Mycotoxigenic Fungi, Methods and Protocols; Moretti, A., Susca, A., Eds.; Humana Press: New York, NY, USA, 2017; Volume 1542 of Methods in Molecular Biology series; pp. 13–32. [Google Scholar]
- Patriarca, A.; da Cabral, L.C.; Pavicich, M.A.; Nielsen, K.F.; Andersen, B. Secondary metabolite profiles of small-spored Alternaria support the new phylogenetic organization of the genus. Int. J. Food Microbiol. 2019, 291, 135–143. [Google Scholar] [CrossRef]
- Wenderoth, M.; Garganese, F.; Schmidt-Heydt, M.; Soukup, S.T.; Ippolito, A.; Sanzani, S.M.; Fischer, R. Alternariol as virulence and colonization factor of Alternaria alternata during plant infection. Mol. Microbiol. 2019, 112, 131–146. [Google Scholar] [CrossRef]
- Barkai-Golan, R.; Paster, N. Mycotoxins in Fruits and Vegetables; Barkai-Golan, R., Nachman, P., Eds.; Academic Press: San Diego, CA, USA, 2008; ISBN 9780123741264. [Google Scholar]
- Elhariry, H.M.; Khiralla, G.M.; Gherbawy, Y.; Elrahman, H.A. Natural occurrence of Alternaria toxins in pomegranate fruit and the influence of some technological processing on their levels in juice. Acta Aliment. 2016, 45, 380–389. [Google Scholar] [CrossRef]
- Ezra, D.; Shulhani, R.; Ya’Akov, I.B.; Harel-Beja, R.; Holland, D.; Shtienberg, D. Factors affecting the response of pomegranate fruit to Alternaria alternata, the causal agent of heart rot. Plant Dis. 2019, 103, 315–323. [Google Scholar] [CrossRef] [PubMed]

| Isolate | Morphotype | Location | Host, Cultivar | Accession Numbers | |||
|---|---|---|---|---|---|---|---|
| ITS | EF-1α | GAPDH | OPA 10-2 | ||||
| AaMR7 | 1 | Italy, Sicily | Punica granatum cv. Wonderful | MW580732 | MW585113 | MW590491 | MW590533 |
| AaMP7a | 1 | Italy, Sicily | Punica granatum cv. Wonderful | MW580733 | MW585114 | MW590492 | MW590534 |
| AaMP10 | 1 | Italy, Sicily | Punica granatum cv. Wonderful | MW580734 | MW585115 | MW590493 | MW590535 |
| AaMR11 | 1 | Italy, Sicily | Punica granatum cv. Wonderful | MW580735 | MW585116 | MW590494 | MW590536 |
| AaMMH6e | 1 | Italy, Sicily | Punica granatum cv. Mollar de Elche | MW580743 | MW585121 | MW590502 | MW590544 |
| AaMP3 | 1 | Italy, Sicily | Punica granatum cv. Wonderful | MW580745 | MW585123 | MW590504 | MW590546 |
| AaMR9a | 1 | Italy, Sicily | Punica granatum cv. Wonderful | MW580747 | MW585125 | MW590506 | MW590548 |
| AaMP9 | 1 | Italy, Sicily | Punica granatum cv. Wonderful | MW580748 | MW585126 | MW590507 | MW590549 |
| AaMDc5b | 1 | Italy, Sicily | Punica granatum cv. Dente di cavallo | MW580754 | MW585132 | MW590513 | MW590555 |
| AaMDc5d | 1 | Italy, Sicily | Punica granatum cv. Dente di cavallo | MW580755 | MW585133 | MW590514 | MW590556 |
| AaMMH6b | 1 | Italy, Sicily | Punica granatum cv. Mollar de Elche | MW580756 | MW585134 | MW590515 | MW590557 |
| AaMMH7a | 1 | Italy, Sicily | Punica granatum cv. Mollar de Elche | MW580757 | MW585135 | MW590516 | MW590558 |
| AaMMH7d | 1 | Italy, Sicily | Punica granatum cv. Mollar de Elche | MW580758 | MW585136 | MW590517 | MW590559 |
| AaMMH6a | 1 | Italy, Sicily | Punica granatum cv. Dente di cavallo | MW580763 | MW585140 | MW590522 | MW590564 |
| AaMMH6d | 1 | Italy, Sicily | Punica granatum cv. Mollar de Elche | MW580764 | MW585141 | MW590523 | MW590565 |
| AaMMH7b | 1 | Italy, Sicily | Punica granatum cv. Mollar de Elche | MW580765 | MW585142 | MW590524 | MW590566 |
| M24-BB1 | 1 | Italy, Apulia | Punica granatum cv. Dente di cavallo | MW580768 | MW585145 | MW590527 | MW590569 |
| M95 A2 | 1 | Italy, Apulia | Punica granatum cv. Wonderful | MW580770 | MW585147 | MW590529 | MW590571 |
| M103 A2-1 | 1 | Italy, Apulia | Punica granatum cv. Wonderful | MW580771 | MW585148 | MW590530 | MW590572 |
| M109 3 | 1 | Italy, Apulia | Punica granatum cv. Wonderful | MW580772 | MW585149 | MW590531 | MW590573 |
| AaMR4 | 2 | Italy, Sicily | Punica granatum cv. Wonderful | MW580739 | MW585117 | MW590498 | MW590540 |
| AaMR12 | 2 | Italy, Sicily | Punica granatum cv. Wonderful | MW580742 | MW585120 | MW590501 | MW590543 |
| AaMR2b | 2 | Italy, Sicily | Punica granatum cv. Wonderful | MW580744 | MW585122 | MW590503 | MW590545 |
| AaMP4 | 2 | Italy, Sicily | Punica granatum cv. Wonderful | MW580746 | MW585124 | MW590505 | MW590547 |
| AaMR14b | 2 | Italy, Sicily | Punica granatum cv. Wonderful | MW580760 | MW585137 | MW590519 | MW590561 |
| AaMP14a | 2 | Italy, Sicily | Punica granatum cv. Wonderful | MW580761 | MW585138 | MW590520 | MW590562 |
| AaMR14a | 2 | Italy, Sicily | Punica granatum cv. Wonderful | MW580766 | MW585143 | MW590525 | MW590567 |
| AaMP14b | 2 | Italy, Sicily | Punica granatum cv. Wonderful | MW580767 | MW585144 | MW590526 | MW590568 |
| M80 B5 | 2 | Italy, Apulia | Punica granatum cv. Wonderful | MW580769 | MW585146 | MW590528 | MW590570 |
| AaMR5b | 3 | Italy, Sicily | Punica granatum cv. Wonderful | MW580731 | MW585112 | MW590490 | MW590532 |
| AaMDc3a | 4 | Italy, Sicily | Punica granatum cv. Dente di cavallo | MW580751 | MW585129 | MW590510 | MW590552 |
| AaMDc3b | 4 | Italy, Sicily | Punica granatum cv. Dente di cavallo | MW580752 | MW585130 | MW590511 | MW590553 |
| AaMDc3c | 4 | Italy, Sicily | Punica granatum cv. Dente di cavallo | MW580753 | MW585131 | MW590512 | MW590554 |
| AaMDc3d | 4 | Italy, Sicily | Punica granatum cv. Wonderful | MW580762 | MW585139 | MW590521 | MW590563 |
| AaMR6b | 5 | Italy, Sicily | Punica granatum cv. Wonderful | MW580740 | MW585118 | MW590499 | MW590541 |
| AaMP6b | 5 | Italy, Sicily | Punica granatum cv. Wonderful | MW580741 | MW585119 | MW590500 | MW590542 |
| AaMDc2a | 5 | Italy, Sicily | Punica granatum cv. Dente di cavallo | MW580749 | MW585127 | MW590508 | MW590550 |
| AaMDc2b | 5 | Italy, Sicily | Punica granatum cv. Dente di cavallo | MW580750 | MW585128 | MW590509 | MW590551 |
| AaMDc1a | 6 | Italy, Sicily | Punica granatum cv. Dente di cavallo | MW580736 | MW585150 | MW590495 | MW590537 |
| AaMDc1b | 6 | Italy, Sicily | Punica granatum cv. Dente di cavallo | MW580737 | MW585151 | MW590496 | MW590538 |
| AaMDc1d | 6 | Italy, Sicily | Punica granatum cv. Dente di cavallo | MW580738 | MW585152 | MW590497 | MW590539 |
| AaMRa1 | 6 | Italy, Sicily | Punica granatum cv. Mollar de Elche | MW580759 | MW585153 | MW590518 | MW590560 |
| Species | Isolate | Country | Host | Accession Numbers a | |||
|---|---|---|---|---|---|---|---|
| ITS | EF-1α | GPDH | OPA 10-2 | ||||
| Alternaria alternata (ex A. citri) | CBS 102.47 | USA | Citrus sinensis | KP124304 | KP125080 | KP124161 | KP124610 |
| Alternaria alternata (ex-type) | CBS 916.96 | India | Arachis hypogaea | AF347031 | KC584634 | AY278808 | KP124632 |
| Alternaria alternata (ex A. limoniasperae) | CBS 102595 | USA | Citrus jambhiri | FJ266476 | KC584666 | AY562411 | KP124636 |
| Alternaria alternata (ex A. tenuissima) | CBS 112252 | - | - | KP124340 | KP125116 | KP124194 | KP124650 |
| Alternaria alternata (ex A. godetiae) | CBS 117.44 | Denmark | Godetia sp. | KP124303 | KP125079 | KP124160 | KP124609 |
| Alternaria gaisen | CBS 118488 | Japan | Pyrus pyrifolia | KP124427 | KP124278 | KP125206 | KP124743 |
| Alternaria alstroemeriae | CBS 118808 | USA | Alstroemeria sp. | KP124296 | KP125071 | KP124153 | KP124601 |
| Alternaria iridiaustralis | CBS 118487 | Australia | Iris sp. | KP124436 | KP125215 | KP124285 | KP124752 |
| Alternaria jacinthicola | CBS 878.95 | Mauritius | Arachis hypogaea | KP124437 | KP125216 | KP124286 | KP124753 |
| Alternaria tomato | CBS 103.30 | - | Solanum lycopersicum | KP124445 | KP125224 | KP124294 | KP124762 |
| Alternaria burnsii | CBS 107.38 | India | Cuminum cyminum | KP124420 | JQ646305 | KP125198 | KP124734 |
| Alternaria alternata (ex A. toxicogenica) | CBS 102600 | USA | Citrus reticulata | KP124331 | KP125107 | KP124186 | KP124640 |
| Alternaria longipes | CBS 540.94 | USA | Nicotiana tabacum | AY278835 | KC584667 | AY278811 | KP124758 |
| Alternaria alternata | CBS 109803 | Germany | human skin | KP124336 | KP125112 | KP124190 | KP124645 |
| Alternaria betae-kenyensis | CBS 118810 | Kenya | Beta vulgaris var. cicla | KP124419 | KP125197 | KP124270 | KP124733 |
| Alternaria eichhorniae | CBS 119778 | Indonesia | Eichhornia crassipes | KP124426 | KP125205 | KP124277 | KP124741 |
| Alternaria arborescens | CBS 109730 | USA | Solanum lycopersicum | KP124399 | KP125177 | KP124251 | KP124713 |
| Alternaria arborescens | CBS 105.24 | - | Solanum tuberosum | KP124393 | KP125171 | KP124245 | KP124706 |
| Alternaria arborescens | CBS 108.41 | - | wood | KP124394 | KP125172 | KP124246 | KP124707 |
| Alternaria arborescens | CBS 112749 | South Africa | Malus domestica | KP124401 | KP125179 | KP124253 | KP124715 |
| Alternaria arborescens | CBS 118389 | Japan | Pyrus pyrifolia | KP124407 | KP125185 | KP124259 | KP124721 |
| Alternaria arborescens | CBS 115517 | South Africa | Malus domestica | KP124404 | KP125182 | KP124256 | KP124718 |
| Primer | Primer DNA Sequence | PCR Conditions | Reference |
|---|---|---|---|
| ITS1 | 5’ TCC GTA GGT GAA CCT GCG G 3′ | 94 °C for 3 min; 94 °C for 30 s, 55 °C for 30 s, 72 °C for 30 s for 35 cycles and final extension at 72 °C for 10 min | [47] |
| ITS4 | 5’ GCT GCG TTC TTC ATC GAT GC 3′ | ||
| EF1-728F | 5’ CAT CGA GAA GTT CGA GAA GG 3′ | 94 °C for 3 min; 94 °C for 30 s, 58 °C for 30 s, 72 °C for 30 s for 35 cycles and final extension at 72 °C for 10 min | [48] |
| EF1-986R | 5’ TAC TTG AAG GAA CCC TTA CC 3′ | ||
| GPD1 | 5’ CAA CGG CTT CGG TCG CAT TG 3′ | 94 °C for 3 min; 94 °C for 30 s, 54 °C for 30 s, 72 °C for 30 s for 35 cycles and final extension at 72 °C for 10 min | [49] |
| GPD2 | 5’ GCC AAG CAG TTG GTT GTG C 3′ | ||
| OPA 10-2R | 5’ GAT TCG CAG CAG GGA AAC TA 3′ | 94 °C for 3 min; 94 °C for 30 s, 62 °C for 30 s, 72 °C for 30 s for 35 cycles and final extension at 72 °C for 10 min | [25] |
| OPA 10-2L | 5’ TCG CAG TAA GAC ACA TTC TAC G 3′ |
| Isolate | Morphotype | Origin | Mycotoxin Concentration (μg/mL) a | ||||
|---|---|---|---|---|---|---|---|
| TeA | AOH | AME | ALT | TEN | |||
| AaMR7 | 1 | Italy, Sicily | 5133 ± 561 | 9.141 ± 1.46 | 2.094 ± 0.22 | 9.177 ± 1.32 | 167.5 ± 31.9 |
| AaMP7a | 1 | Italy, Sicily | 1555 ± 139 | 41.44 ± 7.22 | 26.56 ± 4.01 | 307.8 ± 34.7 | 303.2 ± 13.6 |
| AaMP10 | 1 | Italy, Sicily | 1066 ± 125 | n.d. b | n.d. | n.d. | 91.85 ± 1.76 |
| AaMR11 | 1 | Italy, Sicily | 1889 ± 146 | 38.73 ± 3.95 | 23.98 ± 8.38 | 131.41 ± 13.5 | 214.4 ± 13.1 |
| AaMMH6e | 1 | Italy, Sicily | 279.4 ± 44.6 | 5.619 ± 0.44 | 4.735 ± 0.42 | n.d. | 1.378 ± 0.12 |
| AaMP3 | 1 | Italy, Sicily | 495.6 ± 50.3 | n.d. | n.d. | n.d. | 3.16 ± 0.25 |
| AaMR9a | 1 | Italy, Sicily | 25.61 ± 0.48 | n.d. | n.d. | n.d. | 30.77 ± 2.28 |
| AaMP9 | 1 | Italy, Sicily | 24.13 ± 2.02 | 7.734 ± 0.17 | 4.462 ± 0.18 | 17.98 ± 0.79 | 34.05 ± 4.67 |
| AaMDc5b | 1 | Italy, Sicily | 839.2 ± 65.7 | n.d. | n.d. | n.d. | 12.99 ± 2.02 |
| AaMDc5d | 1 | Italy, Sicily | 3146 ± 256 | 26.50 ± 0.32 | 12.34 ± 1.65 | 83.59 ± 2.33 | 40.80 ± 4.32 |
| AaMMH6b | 1 | Italy, Sicily | 786.8 ± 111 | 6.604 ± 0.29 | 2.451 ± 0.40 | 8.236 ± 1.31 | n.d. |
| AaMMH7a | 1 | Italy, Sicily | 2799 ± 132 | 55.49 ± 3.16 | 14.41 ± 1.21 | 36.82 ± 1.57 | 13.77 ± 0.72 |
| AaMMH7d | 1 | Italy, Sicily | 1004 ± 67.9 | 4.010 ± 1.14 | 3.978 ± 0.72 | 3.464 ± 0.32 | 1.295 ± 0.01 |
| AaMMH6a | 1 | Italy, Sicily | 1606 ± 168 | 57.24 ± 5.39 | 24.06 ± 0.35 | 44.33 ± 4.31 | 19.37 ± 2.13 |
| AaMMH6d | 1 | Italy, Sicily | 1553 ± 70.8 | 83.28 ± 4.30 | 22.71 ± 2.29 | 17.08 ± 0.54 | 3.455 ± 0.58 |
| AaMMH7b | 1 | Italy, Sicily | 2189 ± 149 | 11.64 ± 0.20 | 4.932 ± 0.05 | n.d. | 31.82 ± 0.25 |
| M24-BB1 | 1 | Italy, Apulia | 4204 ± 650 | 222.3 ± 0.14 | 472.7 ± 1.21 | n.d. | 1957 ± 2.67 |
| M95 A2 | 1 | Italy, Apulia | 5204 ± 233 | 161.2 ± 0.25 | 407.3 ± 1.97 | n.d. | 2434 ± 2.78 |
| M103 A2-1 | 1 | Italy, Apulia | 1267 ± 198 | 547.7 ± 0.73 | 604.2 ± 0.60 | n.d. | 1655 ± 28.8 |
| M109 3 | 1 | Italy, Apulia | 3258 ± 7.78 | 384.9 ± 0.09 | 196.5 ± 0.36 | n.d. | n.d. |
| AaMR4 | 2 | Italy, Sicily | 1950 ± 56.5 | 23.82 ± 1.77 | 24.12 ± 4.32 | n.d. | 87.62 ± 4.76 |
| AaMR12 | 2 | Italy, Sicily | 1117 ± 20.9 | n.d. | n.d. | n.d. | 20.80 ± 0.31 |
| AaMR2b | 2 | Italy, Sicily | 1177 ± 44.6 | 3.922 ± 0.64 | 2.209 ± 0.38 | 6.019 ± 0.27 | 3.09 ± 0.86 |
| AaMP4 | 2 | Italy, Sicily | 789.3 ± 113 | n.d. | n.d. | n.d. | 15.19 ± 1.13 |
| AaMR14b | 2 | Italy, Sicily | 952.9 ± 0.34 | n.d. | n.d. | n.d. | n.d. |
| AaMP14a | 2 | Italy, Sicily | 488.2 ± 22.3 | n.d. | n.d. | n.d. | n.d. |
| AaMR14a | 2 | Italy, Sicily | 1169 ± 33.8 | n.d. | n.d. | n.d. | 3.542 ± 0.66 |
| AaMP14b | 2 | Italy, Sicily | 9227 ± 904 | 44.87 ± 2.87 | 6.603 ± 0.27 | n.d. | 5.986 ± 0.59 |
| M80 B5 | 2 | Italy, Apulia | 2987 ± 1.09 | 39.15 ± 0.55 | 73.27 ± 0.68 | n.d. | 8621 ± 37.1 |
| AaMR5b | 3 | Italy, Sicily | 1264 ± 73.0 | 18.29 ± 1.63 | 23.59 ± 1.36 | 112.5 ± 2.51 | 153.2 ± 15.4 |
| AaMDc3a | 4 | Italy, Sicily | 1762 ± 38.6 | 37.64 ± 1.16 | 4.853 ± 0.01 | 17.97 ± 1.06 | 51.69 ± 5.91 |
| AaMDc3b | 4 | Italy, Sicily | 2887 ± 195 | 89.64 ± 2.97 | 10.77 ± 0.10 | 7.465 ± 0.28 | 27.94 ± 2.72 |
| AaMDc3c | 4 | Italy, Sicily | 2336 ± 154 | n.d. | n.d. | n.d. | 64.26 ± 2.55 |
| AaMDc3d | 4 | Italy, Sicily | 2532 ± 214 | 32.55 ± 0.60 | 4.905 ± 0.28 | 9.409 ± 0.40 | 77.48 ± 7.63 |
| AaMR6b | 5 | Italy, Sicily | 1460 ± 83.6 | n.d. | n.d. | n.d. | 235.7 ± 38.1 |
| AaMP6b | 5 | Italy, Sicily | 1115 ± 24.9 | 1.848 ± 0.01 | 4.928 ± 0.43 | 94.28 ± 8.51 | 201.4 ± 20.3 |
| AaMDc2a | 5 | Italy, Sicily | 2028 ± 92.3 | n.d. | n.d. | n.d. | 116.1 ± 6.53 |
| AaMDc2b | 5 | Italy, Sicily | 1840 ± 159 | n.d. | n.d. | n.d. | 51.42 ± 0.19 |
| AaMDc1a | 6 | Italy, Sicily | 2769 ± 207 | 56.18 ± 6.82 | 7.050 ± 1.71 | 425.97 ± 33.2 | n.d. |
| AaMDc1b | 6 | Italy, Sicily | 3918 ± 473 | 18.04 ± 2.17 | 4.074 ± 0.04 | 43.23 ± 0.92 | n.d. |
| AaMDc1d | 6 | Italy, Sicily | 1680 ± 171 | 33.12 ± 4.62 | 2.984 ± 1.26 | 67.54 ± 2.91 | n.d. |
| AaMRa1 | 6 | Italy, Sicily | 2666 ± 19.5 | 76.98 ± 1.37 | 9.974 ± 1.29 | 384.92 ± 42.3 | n.d. |
Publisher’s Note: MDPI stays neutral with regard to jurisdictional claims in published maps and institutional affiliations. |
© 2021 by the authors. Licensee MDPI, Basel, Switzerland. This article is an open access article distributed under the terms and conditions of the Creative Commons Attribution (CC BY) license (http://creativecommons.org/licenses/by/4.0/).
Share and Cite
Aloi, F.; Riolo, M.; Sanzani, S.M.; Mincuzzi, A.; Ippolito, A.; Siciliano, I.; Pane, A.; Gullino, M.L.; Cacciola, S.O. Characterization of Alternaria Species Associated with Heart Rot of Pomegranate Fruit. J. Fungi 2021, 7, 172. https://doi.org/10.3390/jof7030172
Aloi F, Riolo M, Sanzani SM, Mincuzzi A, Ippolito A, Siciliano I, Pane A, Gullino ML, Cacciola SO. Characterization of Alternaria Species Associated with Heart Rot of Pomegranate Fruit. Journal of Fungi. 2021; 7(3):172. https://doi.org/10.3390/jof7030172
Chicago/Turabian StyleAloi, Francesco, Mario Riolo, Simona Marianna Sanzani, Annamaria Mincuzzi, Antonio Ippolito, Ilenia Siciliano, Antonella Pane, Maria Lodovica Gullino, and Santa Olga Cacciola. 2021. "Characterization of Alternaria Species Associated with Heart Rot of Pomegranate Fruit" Journal of Fungi 7, no. 3: 172. https://doi.org/10.3390/jof7030172
APA StyleAloi, F., Riolo, M., Sanzani, S. M., Mincuzzi, A., Ippolito, A., Siciliano, I., Pane, A., Gullino, M. L., & Cacciola, S. O. (2021). Characterization of Alternaria Species Associated with Heart Rot of Pomegranate Fruit. Journal of Fungi, 7(3), 172. https://doi.org/10.3390/jof7030172

